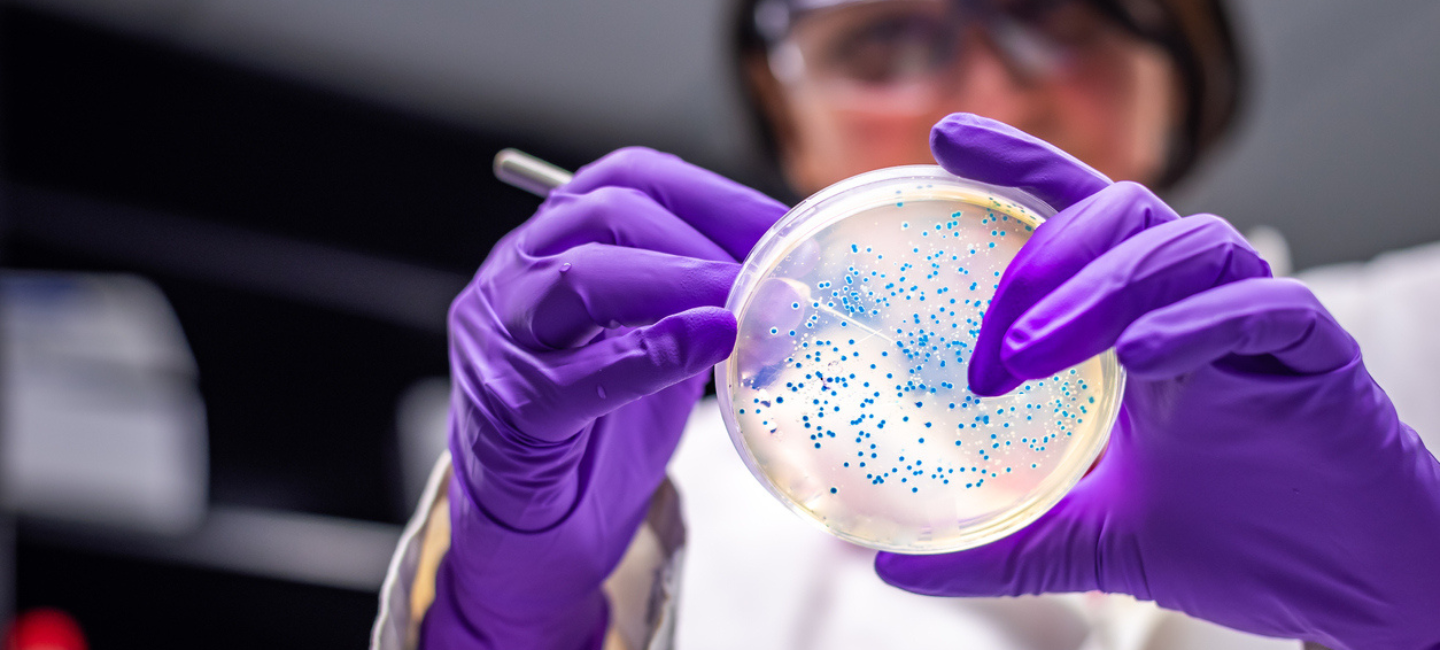

https://www.madrimasd.org/notiweb/noticias 30 enero 2024
¿Puede la evolución ser predecible o no? Un estudio internacional liderado por Alejandro Couce, del Centro de Biotecnología y Genómica de Plantas (CBGP) de la Universidad Politécnica de Madrid (UPM), trata de responder a esta pregunta tomando como ejemplo las mutaciones bacterianas. Sus resultados se publican hoy en la revista internacional Science.
El trabajo arroja luz sobre la pregunta clásica en Biología de si la evolución es totalmente aleatoria o por el contrario puede ser predecible. Lo hace analizando el comportamiento evolutivo de las bacterias y aprovechando las capacidades de análisis que las herramientas genéticas actuales permiten. Los resultados revelan que la evolución de las bacterias puede ser predecible a corto plazo, lo que abre puertas a los esfuerzos por anticiparse a la evolución de patógenos y plagas, así como a posibles aplicaciones biotecnológicas para su control.
En la investigación han participado también la Universidad de Paris (Francia), el Instituto Nacional de Salud e Investigación Biomédica (Francia), la Universidad de Harvard (EEUU), la Universidad de Michigan (EEUU) y el Imperial College de Londres (Reino Unido).
El objetivo principal de los investigadores era estudiar si el efecto de las mutaciones es invariante a lo largo de la adaptación, o por el contrario muestra una gran dependencia histórica. Por ejemplo, si una mutación beneficiosa en el ancestro se puede convertir en perjudicial en los descendientes y viceversa.
El número de mutaciones letales, constante a lo largo de la evolución
Para abordar dicho estudio, los investigadores, emplearon una reciente tecnología de ingeniería genética masiva que permite introducir cientos de miles de mutaciones en bacterias, y estudiar el efecto individual de cada una de ellas. “Esta tecnología permite explorar el efecto, ya sea bueno o malo, de todas las mutaciones posibles a lo largo del genoma bacteriano”, añade Couce.
En su trabajo, los investigadores aplicaron estas técnicas a las bacterias originales(ancestros) y en diferentes estadíos evolutivos del famoso Experimento de Evolución a Largo Plazo, que lleva más de 35 años analizando la evolución de 12 poblaciones de la misma bacteria en condiciones constantes de laboratorio. En total, esas poblaciones fundadas a partir del mismo ancestro, han generado >70,000 generaciones, aproximadamente 5 veces más que las que llevamos los Homo sapiens en la Tierra. La primera gran sorpresa de este nuevo estudio es que la proporción global de mutaciones letales, perjudiciales y neutrales se mantiene prácticamente constante a lo largo de la evolución de esos 12 linajes, a pesar de que la identidad concreta de las mutaciones sí muestra una gran volatilidad.
Para los investigadores, un caso de particular relevancia son las mutaciones letales: mutaciones que como su nombre indica suponen la muerte de quien las sufre, y que revelan qué genes y sistemas son esenciales para la vida. “Los resultados muestran que muchos genes letales en el ancestro dejan de serlo en las estirpes evolucionadas, pero que una fracción similar de mutaciones no letales en el ancestro se vuelven letales más tarde. El resultado, como explica Couce es “que la fracción de mutaciones letales se ha mantenido invariable durante la evolución”.
Esta constancia obliga a replantear modelos acerca del concepto del genoma mínimo, y tiene implicaciones prácticas tanto en biotecnología (creación de bacterias sintéticas), como en medicina (búsqueda de dianas para antibióticos que se mantengan invariables a largo plazo).
Las mutaciones beneficiosas sí han variado
“Partimos de un planteamiento casi filosófico: si pudiésemos conocer todas las mutaciones beneficiosas posibles para un organismo en un momento dado ¿podríamos predecir la adaptación?”, plantea el investigador de la UPM.
“Nuestros resultados muestran que las grandes adaptaciones iniciales son predecibles y que a medida que avanza la evolución esta capacidad se va perdiendo”, explica.
Dado que las grandes adaptaciones iniciales son las que marcan la diferencia entre la supervivencia y la extinción, los resultados obtenidos en este macro estudio suponen una “inyección de moral” a los esfuerzos para predecir la evolución de patógenos, algo que puede aplicarse, por ejemplo, a las bacterias con resistencias múltiples a antibióticos o a nuevos virus pandémicos, o al desarrollo de nuevos métodos de control de enfermedades en agricultura. Además, demuestran que estas nuevas técnicas de ingeniería genética masiva podrían servir para desarrollar en tiempo récord microbios adaptados a diferentes demandas o aplicaciones. Así, por ejemplo, sería posible diseñar bacterias que protejan a las plantas frente a otros patógenos, o bacterias que produzcan o degraden compuestos de interés de forma más efectiva.
“Nuestro trabajo abre las puertas a soñar con que una teoría de la evolución que pueda hacer predicciones concretas es posible, aunque sea solo a nivel estadístico, como sucede con la ciencia del clima”, concluye Couce.
Newsletter
Contacto